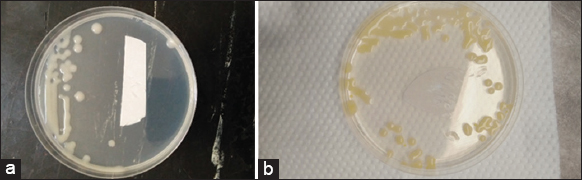

1. INTRODUCTION
Cassava (Manihot esculenta Crantz) supports the livelihoods of most parts in Sub-Saharan Africa [1] and over 800 million people in the tropic [2]. In Kenya, the crop is grown by many households who farm it mainly for its starch-rich tubers but in some communities, its leaves are consumed as a vegetable [3]. In addition, it is a multipurpose crop utilized in numerous industries such as pharmaceutical, food and feed processing, and manufacturing. Unlike many other staple crops, cassava can flourish in nutrient-deprived soils, and harsh climatic conditions, and it is tolerant to most pests and diseases [4]. Nonetheless, its prospects as a food security as well as an economic crop continues to be dimmed by cassava bacterial blight (CBB) caused by Xanthomonas phaseoli pv manihotis (syn. Xanthomonas axonopodis pv manihotis) and X. axonopodis pv cassavae which can lead to 100% loss depending on environmental conditions [5]. Despite it being known to exist in Kenya its distribution in many growing areas remains unknown [6]. However, a recent survey by [7,8] in the coastal regions of Kilifi and Taita taveta has revealed that the disease is present on farms with incidences of up to 100%. Furthermore, most of the research has focused on the distribution of only X. phaseoli pv manihotis without considering X. axonopodis pv cassavae which is also associated with bacterial blight. Therefore, this study was conducted to determine the effect of farmers’ knowledge and production practices on the intensity of CBB in Western Kenya a prime cassava-growing region in Kenya [3].
2. MATERIALS AND METHODS
2.1. Study Area
The survey covered two agro-ecological zones in Nambale Lower midland zone 1 (LM1) and Teso South Lower midland zone 2 (LM2) in Western Kenya. These areas are associated with a temperature range of 21–30, two rainfall seasons with a typical precipitation of 760 and 1750 mm, the soils are well-drained, deep, brownish, and sandy, the altitude ranges between 1200 and 1440 m above sea level [9]. Most of the farmers do non-commercial farming mainly growing cassava, sorghum, and maize either singly or intercropped. The study was conducted in the month of November 2020.
2.2. Survey of Cassava Farming Households
A multistage approach was used to select 193 farmers for the survey. In the first stage, two agro-ecological zones LM1 and LM 2 were purposively identified due to their high cassava production. In the second stage, two sub counties Nambale (from LM1) and Teso South (from LM2) were purposively selected, one from each agro-ecological zone. In the third stage, four wards were selected from Teso south and Nambale sub counties. In the fourth stage, 20–30 households were randomly selected within each ward through the aid of field guides. The distance from one household to the next was 2 km. Data on cassava production methods and CBB awareness among farmers were acquired using a semi-structured questionnaire while field assessment was also done to determine the distribution of CBB on the visited farms. The interviews were conducted using Kiswahili and the local language (Teso). Pictures of common cassava pests and diseases were shown to the farmers to obtain their knowledge on pests and diseases. Data on disease management practices, sources of cassava stem cuttings, sources of information on cassava production, knowledge on CBB, and cassava production techniques were sought from the farmers. Geographical coordinates were also collected and recorded from each of the visited farms. The sample size was determined using the following formula [10] where P = 0.5, Z = 1.96, and E = 0.071
 |
2.3 Determination of CBB Intensity
Cassava plants were assessed for CBB along two diagonals within the farm by randomly selecting 30 plants [11]. The disease incidence was determined as the number of plants exhibiting CBB symptoms over the total number of plants assessed multiplied by 100% to obtain the percentage:
 |
Disease severity was assessed using a 1–5 scale [12] where 1 = no symptoms, 2 = angular leaf spotting only, 3 = wilting, angular leaf spot, leaf blight, defoliation, and gum exudates on stems or petioles, 4 = wilting, blighting, defoliation, gum exudation, and shoot tip die back, and 5 = wilting and blighting, defoliation and gum exudation, abortive lateral shoot formation, stunting, and complete dieback. Leaves showing CBB symptoms were plucked, placed as composite samples to representing each farm in khaki bags, and stored at 4 before isolation of the CBB causal agents.
2.4. Isolation and Confirmation of CBB Causal Agents
Sections containing healthy and diseased parts were cut from diseased leaves and surface sterilized using 0.5% sodium hypochlorite followed by rinsing thrice in sterile distilled water. The tissues were macerated using sterile glass rods in 5 mL sterile distilled in universal bottles. The macerate was then streaked on yeast peptone glucose agar (YPGA) [13] and incubated for 24 h. The bacterial colonies were purified and subjected to morphological, biochemical, and pathogenicity tests to identify and confirm the CBB causal agents [8,14-16]. The biochemical characteristics determined included Gram stain, potassium hydroxide solubility, utilization of sucrose, lactose cellobiose, and catalase test. Pathogenicity tests were done by spraying 4-weeks old healthy cassava plant with 106 CFU/mL suspension of each isolate.
2.5. Data Analysis
The socioeconomic data from the survey questionnaires were analyzed using IBM® the Statistical Packages for the Social Sciences, version 21. Both descriptive statistics and the Chi-square test were used to describe the different variables and determine if there was any association between the variable and CBB [17].
3. RESULTS
3.1. Sociodemographic Characteristics and Production Practices
The results indicated that cassava is mostly farmed by women despite more than 60% of the households being male-dominated in both sub counties. Majority of the farmers are middle-aged (36–51 years) and with primary education at (20%) as in both sub counties surveyed. Farming was the main source of employment for over 80% of the respondents and most of the farmers (88%) had over 5 years’ experience in cassava farming [Figure 1]. Over 60% of the farmers grow cassava on less than two acres of land with non-mechanized cultivation. Over 60% of the farmers obtained cassava planting materials from older plants within their farms or from neighbors. However, in Teso South, 23% of the farmers obtained cassava cuttings from Kenya Agricultural and Livestock Research Organization [Figure 2].
 | Figure 1: Sociodemographic characteristics of cassava farmers in Busia County. [Click here to view] |
 | Figure 2: Cassava production practices in Busia County. [Click here to view] |
3.2. Isolated Causal Agents of CBB
The two bacterial isolates had white, mucoid, shiny convex colonies, and yellow, mucoid, shiny, convex, and colonies [Figure 3]. The cells were rod-shaped, Gram-negative, catalase positive, motile, and KOH positive. They were capable of utilizing glucose, and sucrose, but incapable of breaking down lactose and cellobiose [Table 1]. Pathogenicity tests of the two causal agents confirmed the two bacterial causal agents as X. phaseoli pv manihotis and X. axonopodis pv cassavae.
| Figure 3: (a) White colony of Xanthomonas phaseoli pv manihotis. (b) Yellow colony of Xanthomonas axonopodis pv cassavae after 24 h on YPGA Media [Click here to view] |
Table 1: Morphological and physiological characteristics of isolated cassava bacterial blight causal agents.
| Parameters | Cassava bacterial blight causal agents | |
|---|---|---|
| Xanthomonas phaseoli pv manihotis | Xanthomonas axonopodis pv cassavae | |
| Colony traits | ||
| Pigmentation | White | Yellow |
| Margin | Entire | Entire |
| Motility | Motile | Motile |
| Elevation | Convex | Convex |
| Shape | Rod-shaped | Road shaped |
| Surface | Mucoid | Mucoid |
| Physiological characteristics | ||
| Gram stain | Negative | Negative |
| Sucrose Utilization | Positive | Positive |
| Lactose utilization | Negative | Negative |
| Cellobiose utilization | Negative | Negative |
| Catalase test | Positive | Positive |
3.3. Pathogenicity of the Isolated CBB Causal Agents
Cassava plants inoculated with the white bacteria had drooped leaves showing angular leaf spots which amalgamated to form blight 6-days post-inoculation. It also caused systemic infection in contrast to the yellow bacterial isolate that only formed angular leaf spots by the 14th day post-inoculation and was limited to the foliar parts of the cassava plant. The pathogenicity test showed that the white and yellow colonies were X. phaseoli pv manihotis (XPM) and X. axonopodis pv cassavae (XAC), respectively [Figure 4]. From the isolations, 178 of XPM and 10 of XAC showed virulence.
 | Figure 4: (a and b) Blighted leaves, complete death in plants infected Xanthomonas phaseoli pv manihotis. (c) Angular leaf spots on plants infected Xanthomonas axonopodis pv cassavae. (d) Control plant inoculated with sterile distilled water. [Click here to view] |
3.4. Prevalence and Intensity of CBB in Western Kenya
CBB was found to be prevalent in Western Kenya with both causal agents present across both sub-counties surveyed [Figures 5 and 6]. More than 80% of the farms assessed had a severity score of 3 with over 70% of the farmers incapable of identifying CBB in both sub-counties surveyed [Table 2]. Bacterial blight causal bacteria were isolated from 94% of the 193 samples while the remaining 6% may have been negative due to spoilage of samples. Of the two, X. phaseoli pv manihotis (XPM) was more widespread as compared to X. axonopodis pv cassavae (XAC) [Figure 5]. Moreover, from each sub-county the number of farms from which each causal agent was isolated was as follows; Teso South: XPM 76 and XAC 2 and Nambale: XPM 95, XAC 8 and XPM plus XAC 1 [Figure 6].
 | Figure 5: Incidence of cassava bacterial blight across Busia County. [Click here to view] |
 | Figure 6: Distribution of cassava bacterial blight causal agents Xanthomonas phaseoli pv manihotis (XPM) and Xanthomonas axonopodis pv cassavae (XAC) in Busia County. [Click here to view] |
Table 2: Cassava bacterial blight perception in different cassava farms.
| Characteristics | Sub-counties | ||
|---|---|---|---|
| Teso South (%) | Nambale (%) | Pooled (%) | |
| Famers knowledge | |||
| Aware | 23.8 | 10.1 | 16.1 |
| Unaware | 76.2 | 89.9 | 83.9 |
| Severity score | |||
| 2 | 23.9 | 0.0 | 10.8 |
| 3 | 76.1 | 100.0 | 89.2 |
3.5. Association between Bacterial Blight Incidence and Sociodemographic Characteristics of the Farmers
The association between incidence, training, seed source, and intercrop was neither significant (P > 0.005) nor strong as the confidence interval values included 1. This indicated that other factors as causes of elevated the CBB incidence [Table 3].
Table 3: Association between training and incidence of cassava bacterial blight.
| Factor | Percentage of Respondents with high incidence | P-value | odd ratio | 95%CI |
|---|---|---|---|---|
| Trained | 86 | 0.405 | 0.695 | (0.295–1.641) |
| KALRO cuttings | 89 | 0.461 | 0.619 | (0.171–2.238) |
| Neighbors cuttings | 85 | 0.671 | 0.831 | (0.353–1.954) |
| Recycled cuttings | 75 | 0.086 | 0.453 | (0.181–1.136) |
| Maize intercrop | 83 | 0.594 | 1.28 | (0.515–3.182) |
| Millet intercrop | 80 | 0.402 | 1.485 | (0.586–3.763) |
| Beans intercrop | 85 | 0.9 | 0.945 | (0.396–2.260) |
| Groundnuts intercrop | 77 | 0.14 | 1.941 | (0.797–4.727) |
| Soya intercrop | 78 | 1.181 | 1.851 | (0.745–4.599) |
4. DISCUSSION
The study showed that cassava is mainly cultivated by women despite most households being male led. Majority of the farmers were middle-aged and no major difference in the level of education was noted across both sub counties as most farmers had been schooled up to the primary. In addition, cassava farming was primarily conducted for subsistence and many of the farmers had more than 5 years of experience. This concurs with findings by [17-19] who discovered similar trends in other cassava areas. Furthermore, cassava is mainly cultivated on two acres in a non-mechanized fashion [20]. Reported land fragmentation and preference for other crops deemed more valuable led to the allocation of a small land portion to cassava. The study also established that many farmers depend on uncertified seed systems. However, more farmers from Teso South accessed certified seed from institutions like KALRO in contrast to Nambale. This might be because farmers in Teso South are closer to KALRO than those from Nambale. This aligns with studies by [20-22] who observed that distance determines access to certified cassava cuttings by the farmer because those far from clean cutting sources will mainly rely on uncertified seed systems which are marked by recycled cuttings leaving them exposed to pests and diseases which might latently surviving in such cuttings.
After 24 h of growth, two bacterial isolates with white and yellow colonies were observed on YPGA media. These traits recorded in other studies have been cited as a basis for distinguishing CBB causal agents [14]. However, [6] has reported that colony color may change after 3–4 days which was not observed in the study as the colony color remained stable for both isolates post 4 days. The two isolates had convex colonies with entire margins, and a glossy surface which concurs with reports by [8] when they assessed isolates from the coastal region of Kenya. The two isolates degraded sucrose, glucose, and maltose but none could break down lactose or cellobiose. Slight variations in the utilization of maltose have been recorded as X. axonopodis pv cassavae has been shown to degrade the sugar slower than X. phaseoli pv manihotis [15,21]. However, this was not recorded in the study. Nonetheless, none of these biochemical tests could reliably differentiate the two bacterial isolates to pathovar level and this was the case in the study [6]. Therefore, pathogenicity tests were conducted as both the white (X. phaseoli pv manihotis) and yellow (X. axonopodis pv cassavae) have been reported to differ in their virulence.
The pathogenicity tests showed that X. phaseoli pv manihotis is more severe of the two isolates. Xanthomas phaseoli pv manihotis is capable of systemic infection, leading to plant death 6-day post-inoculation. However, X. axonopodis pv cassavae cannot cause systemic infection because it is limited to the foliar parts of the plant causing angular leaf spots. Its disease progress is slower than X. phaseoli pv manihotis as diseased plants started showing symptoms 14-day post-inoculation in contrast to X. phaseoli pv manihotis in which infected plants started exhibited symptoms 6 days’ after infection. These results are consistent with records by [14,22] who observed a similar trend when they inoculated plants with both bacteria. Although pathogenicity was able to distinguish the pathogens on the basis of virulence and symptomatology, it did not distinguish the two isolates up to the pathovar level.
Moreover, the survey revealed that CBB is prevalent in western Kenya with the majority of the farmers unaware of the disease despite its regional existence as early as the 1980s. This concurs with studies by [6-8] who have reported incidences of over 70% at farm level in other cassava regions in Kenya. Furthermore, from the laboratory isolations, both causal agents of CBB were recovered from Busia of which X. phaseoli pv manihotis was more widespread compared to X. axonopodis pv cassavae. This agrees with findings by [21,23] who suggested X. phaseoli pv manihotis is more dominant probably because its more virulent in contrast to X. axonopodis pv cassavae; however, they observed that the latter bacteria can incite severe disease in certain environmental conditions. Interestingly, there was no association between the sociodemographic traits or cassava production practices with the high prevalence of CBB observed in Western Kenya indicating that other reasons contribute to its spread.
It has also been observed that limited CBB knowledge among farmers leads to the spread of the disease resulting in its buildup in the long run [14]. This aligns with the results of the study where most farmers responded as never having encountered CBB. The ignorance might be because more focus has been placed on other cassava diseases at the expense of CBB revealed by the fact that most farmers in the study could easily identify other cassava pests and diseases and even relate them to their respective symptoms [24,25]. Similar observations were made in the Kenyan coast where though most farmers 61% were able to recognize the symptoms none could link them to CBB [8]. Therefore, ignorance might be the main reason why most farmers are not applying existing control measures leading to increased CBB prevalence overtime as most of the farmers reported that they are dependent on cuttings from informal seed systems [26,27]. Depravity in soil fertility has been connected to CBB; however, it has been shown that the addition of certain compounds into the soils improves cassava resilience against CBB [28]. However, most farmers cannot afford such fertility inputs due to financial constraints [29,30]. Lack of access to improved cultivars has also been linked to increased CBB presence which is the case of most farmers in Sub-Saharan Africa including Kenya leaving them vulnerable in the event of an epidemic [5].
5. CONCLUSION
The study shows that CBB and its causal agents are spread extensively in Busia Western Kenya a prime cassava production area. This could have been largely contributed to by the fact that most farmers are ignorant of the disease hence apply no control measures. Furthermore, none of the characterization methods used in the study could characterize both bacteria to the pathovar level. Which therefore necessitates that appropriate action be taken for farmers to be made aware and receive up-to-date information on the disease. More robust methods like molecular methods ought to be used to characterized and distinguish both pathogens in Kenya.
6. ACKNOWLEDGMENT
The authors wish to acknowledge the Busia County agricultural staff for their support in the survey, the MasterCard foundation and the Regional Universities Forum for Capacity Development (RUFORUM) for funding the Cassava project: Community Action Programme Plus Four (CARP+4) and the farmers without whom no data would be collected.
7. AUTHORS’ CONTRIBUTIONS
All authors made substantial contributions to conception and design, acquisition of data, or analysis and interpretation of data; took part in drafting the article or revising it critically for important intellectual content; agreed to submit to the current journal; gave final approval of the version to be published; and agreed to be accountable for all aspects of the work. All the authors are eligible to be an author as per the International Committee of Medical Journal Editors (ICMJE) requirements/guidelines.
8. CONFLICTS OF INTEREST
The authors report no financial or any other conflicts of interest in this work.
9. ETHICAL APPROVALS
This study did not involve experiments on animals or human subjects.
10. DATA AVAILABILITY
The raw data supporting the conclusions of this article will be made available by the authors upon request.
11. PUBLISHER’S NOTE
This journal remains neutral with regard to jurisdictional claims in published institutional affiliation.
REFERENCES
1. Spencer DS, Leone S, Ezedinma C. Cassava Cultivation in Sub-Saharan Africa. Cambridge:Burleigh Dodds Science Publishing Limited;2017. 123-48. [CrossRef]
2. Mbanjo EG, Rabbi IY, Ferguson ME, Kayondo SI, Eng NH, Tripathi L, et al. Technological innovations for improving cassava production in sub-saharan Africa. Front Genet 2021;11:623736. [CrossRef]
3. Ouma JO, Abong'GO, Ngala S. Contribution of cassava and cassava-based products to food and nutrition security in Migori county, Kenya. Afr J Food Agric Nutr Dev 2021;21:17379-414. [CrossRef]
4. Soto Sedano JC, Mora Moreno RE, Mathew B, Léon J, Gómez Cano FA, Ballvora A, et al. Major novel QTL for resistance to cassava bacterial blight identified through a multi-environmental analysis. Front Plant Sci 2017;8:1169. [CrossRef]
5. Bart RS, Taylor NJ. New opportunities and challenges to engineer disease resistance in cassava, a staple food of African small-holder farmers. PLoS Pathog 2017;13:e1006287. [CrossRef]
6. Odongo HM, Miano DW, Muiru WM, Mwang'ombe AW, Kimenju JW. Distribution of cassava bacterial blight and reaction of selected cassava genotypes to the disease in Kenya. J Nat Sci Res 2019;9:36.
7. Chege MN, Wamunyokoli F, Kamau J, Nyaboga EN. Phenotypic and genotypic diversity of Xanthomonas axonopodis pv. Manihotis causing bacterial blight disease of cassava in Kenya. J Appl Biol Biotechnol 2017;5:38-44.
8. Livoi A, Mwang'ombe AW, Nyaboga E, Kilalo D, Obutho E. Prevalence and distribution of cassava bacterial blight in the Kenyan coast. Agric Sci 2021;3:7-14. [CrossRef]
9. Owiny MO, Obonyo MO, Gatongi PM, Fèvre EM. Prevalence and spatial distribution of Trematode cercariae in vector snails within different agro-ecological zones in Western Kenya, 2016. Pan Afr Med J 2019;32:142. [CrossRef]
10. Anderson DR, Sweeney DJ, Williams TA, Camm JD, Cochran JJ. Statistics for Business and Economics. Boston:Cengage Learning;2016.
11. Sseruwagi P, Sserubombwe WS, Legg JP, Ndunguru J, Thresh JM. Methods of surveying the incidence and severity of cassava mosaic disease and whitefly vector populations on cassava in Africa:A review. Virus Res 2004;100:129-42. [CrossRef]
12. Wydra K, Banito A, Kpémoua KS. Characterization of resistance of cassava genotypes to bacterial blight by evaluation of leaf and systemic symptoms in relation to yield in different ecozones. Euphytica 2007;155:337-48. [CrossRef]
13. Azorji JN, Igwe CE, Kanu C. Screening of Selected improved cassava varieties for bacterial blight and varietal performance under natural environment in Ibadan, South-Western Nigeria. Int J Sci Technoledge 2016;4:63-9. [CrossRef]
14. Zárate-Chaves CA, de la Cruz DG, Verdier V, López CE, Bernal A, Szurek B. Cassava diseases caused by Xanthomonas phaseoli pv. Manihotis and Xanthomonas cassavae. Mol Plant Pathol 2021;22:1520-37. [CrossRef]
15. Ogunjobi A, Fagade O, Dixon A, Amusa NA. Pathological variation in cassava bacterial blight (CBB) isolates in Nigeria. World Appl Sci J 2007;2:587-93.
16. Reiner K. Catalase Test Protocol. Washington, DC:American Society for Microbiology;2010. 1-6.
17. Kidasi PC, Chao DK, Obudho EO, Mwang'ombe AW. Farmers'sources and varieties of cassava planting materials in coastal Kenya. Front Sustain Food Syst 2021;5:1-14. [CrossRef]
18. Nyirakanani C, Bizimana JP, Kwibuka Y, Nduwumuremyi A, de Paul Bigirimana V, Bucagu C, et al. Farmer and field survey in cassava-growing districts of rwanda reveals key factors associated with cassava brown streak disease incidence and cassava productivity. Front Sustain Food Syst 2021;5:699655. [CrossRef]
19. Tirra AN, Oluoch-Kosura W, Nyanganga H, Mwang'ombe AW. Determinants of participation decision in cassava marketing by smallholder farmers in Taita-Taveta and Kilifi counties, Kenya. J Agric Sci 2019;11:98-109. [CrossRef]
20. Coulibaly ON, Arinloye AD, Faye M, Abdoulaye T, Calle-Goulivas A, Ahoyo R. Regional Cassava Value Chains Analysis In West Africa Case Study Of Cote-D'ivoire. Ibadan:International Institute of Tropical Agriculture 2014, 51-7. Available from:https://www.researchgate.net/publication /269988165_REGIONAL_CASSAVA_VALUE_CHAINS_ANALYSIS_IN_WEST_AFRICA_CASE_STUDY_OF_SIERRA-LEONEDO [Last accessed on 2023 Jun 05].
21. Van den Mooter M, Maraite H, Meiresonne L, Swings J, Gillis M, Kersters K, et al. Comparison between Xanthomonas campestris pv. Manihotis (ISPP list 1980) and X. campestris pv. Cassavae (ISPP list 1980) by means of phenotypic, protein electrophoretic, DNA hybridization and phytopathological techniques. Microbiology 1987;133:57-71. [CrossRef]
22. Pereira LF, Goodwin PH, Erickson L. Peroxidase activity during susceptible and resistant interactions between Cassava (Manihot esculenta) and Xanthomonas axonopodis pv. Manihotis and Xanthomonas cassavae. J Phytopathol 2000;148:575-8. [CrossRef]
23. Mukunya DM, Onyango DM. Distribution and Importance of Xanthomonas manihotis and X. cassavae in East Africa;1980. 23-7. Available from:https://www.erepository.uonbi.ac.ke/handle/11295/34208 [Last accessed on 2023 Jun 05].
24. Alonso Chavez V, Milne AE, van den Bosch F, Pita J, Mcquaid CF. Modelling cassava production and pest management under biotic and abiotic constraints. Plant Mol Biol 2021;109:325-49. [CrossRef]
25. Ng'ang'a PW, Miano DW, Wagacha JM, Kuria P. Identification and characterization of causative agents of brown leaf spot disease of cassava in Kenya. J Appl Biol Biotech 2019;7:1-7. [CrossRef]
26. Mbaringong GA, Nyaboga EN, Wang'ondu V, Kanduma E. Evaluation of selected cassava (Manihot esculenta crantz) cultivars grown in Kenya for resistance to bacterial blight disease. World J Agric Res 2017;5:94-101.
27. Buthelezi MN, Ngobeni ND. A survey of farming practices and cassava pests and diseases:A case study for Mseleni village, Kwazulu-natal in South Africa. Indilinga Afr J Indig Knowl Syst 2015;14:262-71.
28. Njenga KW, Nyaboga E, Wagacha JM, Mwaura FB. Silicon induces resistance to bacterial blight by altering the physiology and antioxidant enzyme activities in cassava. World J Agric Res 2017;5:42-51.
29. Mdenye BB, Kinama JM, Olubayo FM, Kivuva BM, Muthomi JW. Effect of storage methods on carbohydrate and moisture of cassava planting materials. J Agric Sci 2016;8:100-11. [CrossRef]
30. Houngue JA, Pita JS, CacaïGH, Zandjanakou-Tachin M, Abidjo EA, Ahanhanzo C. Survey of farmers'knowledge of cassava mosaic disease and their preferences for cassava cultivars in three agro-ecological zones in Benin. J Ethnobiol Ethnomed 2018;14:29. [CrossRef]